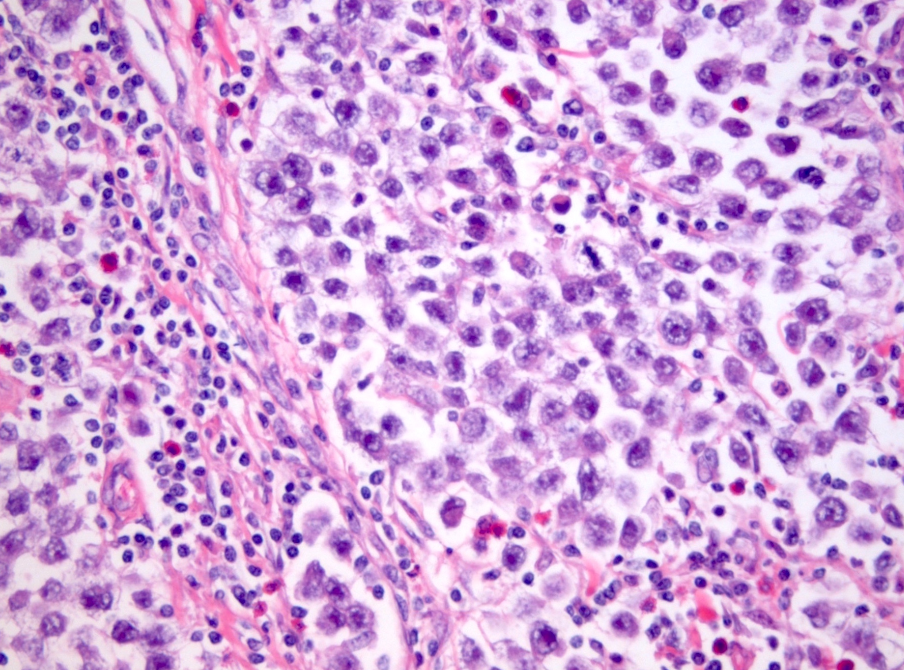

Where in the penis is this histology demonstrative of?

Corpora cavernosa
High power view of interanastamosed slit-like vascular spaces with thin muscular walls.
Complex tridimeensional network of trabeculae.
Vessel walls: thick bundles of smooth muscle. The vascular structures of the corpora cavernosa are thicker adn more complex when compared with those of the corpus spongiosum.
Why is it important to histologically separate corpus spongiosum from cavernosum?
Because tumours affecting cavernosum are a/w a higher rate of nodal metastasis.
Anatomical location?
Describe histological composition?
Describe key anatomical feature?

Litter glands (intraepithelial mucous glands) emptying into urethra.
Urethra surrounded by periurethral cylinder
Urethral epithelium (stratified with columnar celll ayer at the surface, devoid of umbrella cells) -> LP -> corpus spongiosum, albuginea and Buck fascia.
Periurethral mucinous Littre glands
Penioe lesion
Dx:
Histo features

Penile linear schlerosis -> precursor to Lichen sclerosis/
Moderate lymphcytic infiltrate in LP.
Dx:
Feature:

Lichen Sclerosis
Basal vacuolation seen just above the linear sclerosis of the basal membrane.
Dx:
Histo features:

Classic or band-like lichen sclerosis
Features: Sclerotic band replacing the LP is located between the epithelium and a dense and diffuse lymphocytic infiltrate located below.
Dx:
Key histo features:

Lichen sclerosis
Normal to atrophic epithelium covering a band of diffuse sclerosis in the lamina propia overlying a dense and continuous band of lymphocytes. Note the vacuolization of basal cells and the globular perivascular hyalinization at the epithelial-stromal interface.
Dx

LS (lymphocytic depletion subtype)
Sclerotic band replacing the lamina propria, globular and perivascular hyalinization and scarce lymphocytic infiltrate is seen. The overlying epithelium shows moderate atypia, corresponding to differentiated penile intraepithelial neoplasia.
Section from prostate bx
Dx?

Cowper’s glands
From testicular mass.
Histo features?
Dx?
Seminoma
Histo: Large cells with clear cytoplasm and squared off nuclei and prominent nucleoli admixed with inflammatory cells (lymphocytes and plasma cells in fibrous bands)
Incidental finding in bladder bx?
Dx?
Histo features?
Cause?

Dx: nephrogenic adenoma
Cause: metaplastic change of the urothelium in response to chronic infection, calculi, or prolonged catheterization. Sometimes implants.
Histo: : heterogeneous with numerous architectural patterns that are often admixed including small tubular, papillary, sheet-like with clear cytoplasm (diffuse), fibromyxoid, and flat. The lesional cells are low cuboidal and may have a hobnail arrangement in tubules or on papillae; thick BM material often surrounds the tubules. Small tubules often have an intraluminal blue myxoid material that may simulate a signet ring cell.

PCCRT is diffusely positive for CK7 and exhibits cup-like staining for CAIX with no luminal border staining. GATA3 may be positive, as are PAX2, PAX8, and 34βE12. AMACR and CD10 are negative or only patchy.
Morphology: luminal nuclei. pT1 tumour (grade 1 or 2).
ccRCC:
Inactivation of the VHL complex is the defining signature event in CCRCC, Loss of 3p .CAIX (CA9) is part of the hypoxia pathway related to VHL and shows extensive membranous immunohistochemical labelling diffusely throughout the tumour (circumferential), contrasting with the usually focal labelling associated with necrosis or ischaemia in other tumour types. CK7 usually shows negative or only focal labelling in CCRCC, but it often marks cystic areas
Bladder CIS vs reactive epithelium
IHC to differentiate?
CK20, p53, Ki67, CD44
decreased labelling for CD44 in CIS (basal only or absent, in contrast to full-thickness labelling in reactive urothelium)
Ki67 is a less established marker in WHO blue book

bladder bx. smoker.
dx?
Diagnostic features?

Urothelial carcinoma in situ.
High-grade malignant urothelial cells with markedly atypical nuclear features (recognizable at low to intermediate magnification) with no papillary formation.
In CIS, the neoplastic cells need not occupy the full thickness of the mucosa. The presence of unequivocally malignant isolated cells interspersed within benign urothelium (i.e. pagetoid spread) or of cells undermining the overlying benign urothelial layer cells is sufficient for the diagnosis.
60M bladder bx
DX?

Urothelial CIS.
Adjacent urothelium is denuded (often the case). Don’t need full-thickness atypia.
bladder bx
dx?
Key features?
Aetiology?

Cystitis cystica.
Superficial nests of urothelial mucosa with cystic change in the b/g of chronic inflammation. Often exhibit a vaguely lobular architecture, non-infiltrative growth and connection to overlying epithelium. Cells lack significant atypia, mitotic activity, stromal reaction and muscular invasion.
Aetiology: chronic irritation/local inflammatory insult
Dx?
Aetiology?
Key features?
IHC?

Nephrogenic adenoma/metaplasia.
Injury to urothelium.
Tubules lined by simple cuboidal, flattened or hobnail cells, forming an exophytic papillary or endophytic lesion
Associated acute and chronic inflammation and edema in the stroma; lack of desmoplastic reaction
multiple patterns: tubular, tubulocystic, polypoid, flat, fibromyxoid, signet ring cell-like
Hyaline rim surrounds the tubules (PAS positive thickened basement membrane)
No mitotic activity
IHC: PAX8(+), CK7(+), AMACR(+), EMA(+)
59M. Testicular mass
Dx?
Key features?

Dx: Spermatocytic tumour
Incidence peaksin the the sixth decade of life, with a mean age of 52–59 years. The tumours are rare in teenage boys and non-existent in children.
The most characteristic feature is a polymorphous cell population, often described as tripartite, consisting of three distinct cell types with distinguishing features based on cell size and chromatin: the small cells exhibit round, uniformly dense nuclei and scant cytoplasm; intermediate-sized cells have round nuclei with finely granular to filamentous (spireme) chromatin and variably prominent nucleoli; and giant cells have single or multiple nuclei with similar nuclear features to those of the intermediate-sized cells. Mitotic figures, including atypical forms, are usually frequent, as are a large number of apoptotic tumour cells. Unlike in a classic seminoma, prominent lymphocytic infiltrates are not present, and granulomatous inflammation is only rarely seen. Intratubular growth is common, but GCNIS is absent.
Essential: spermatocytic tumours typically occur in an older age group, with most patients in their fifth or sixth decade; tripartite microscopic appearance with three distinct cell types and without lymphocytic infiltrate or prominent fibrous septa; no immunoreactivity for usual embryonic germ cell tumour markers; no GCNIS.

Testicular tumour
pathological staging?

testicular mass 30M
Dx?
Key features?
IHC?

Embryonal carcinoma.
The key diagnostic feature is the cell type: large pleomorphic, epithelioid cells with vesicular nuclei containing macronucleoli (one or more), mitotic figures, and dense amphophilic cytoplasm. Nuclei frequently overlap and there is often a syncytial appearance without well-defined cell borders.
IHC: Embryonal carcinomas consistently express CD30 (membrane), OCT3/4 (nuclear), SALL4, and AE1/AE3. CD30 may be lost in metastases, but OCT3/4 is maintained in lymph node metastases after chemotherapy
Syncytiotrophoblastic giant cells frequently seen in EC (46% of cases)
Embryonal carcinoma
How can you distinguish intratubular spread from LVSI with IHC?
The distinction between intratubular spread and lymphovascular invasion may require immunohistochemistry (CD34 for basement membranes of tubules, CD31 for blood vessel endothelia, and D2-40 for lymphatic vessel endothelia).
Describe the gross anatomical layers of the testis

Embryonal ca vs chorio
46% of EC show syncytiotrophoblasts. How can you distinguish EC from chorio in this instance?
OCT3/4 staining in embryonal carcinoma, and its absence in the cytotrophoblast of choriocarcinoma, is the most useful distinguishing feature.
Embryonal ca vs seminoma
Some embryonal carcinomas (11%) show a seminoma-like pattern, how can you distinguish this from true seminoma?
AE1/AE3 and CD30 staining is diffuse/strong in embryonal carcinoma, but AE1/AE3 is patchy/weak in seminoma and CD30 should be negative or only very focally positive. PLAP, D2-40, and KIT (CD117) are diffusely positive in seminoma but should be negative (or can be patchy) in embryonal carcinoma. OCT3/4 is consistently expressed in seminoma and embryonal carcinoma and thus does not help in the distinction. SOX2 is a specific marker for embryonal carcinoma, staining 96% of embryonal carcinomas and < 1% of seminomas




























































